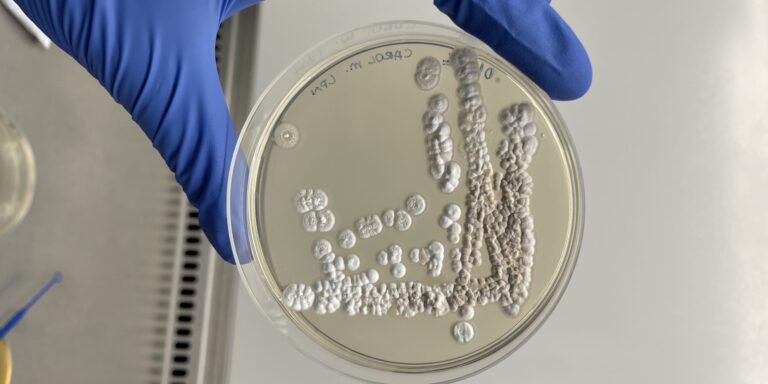
noticias_generica_lnbio-premio-genetica-2023-scaled

Pós-graduanda do CNPEM é premiada em mostra científica da UNICAMP
A estudante Julia Silva Souza, integrante do Grupo de Espectroscopia e Cromatografia Avançada do LNBio/CNPEM e pós-graduanda da Faculdade de Ciências Farmacêuticas da UNICAMP, conquistou o primeiro lugar na categoria de pós-graduação da X Mostra de Trabalhos Científicos, realizada durante a XX Semana Acadêmica de Farmácia da UNICAMP. Sob orientação de Silvana Aparecida Rocco e…